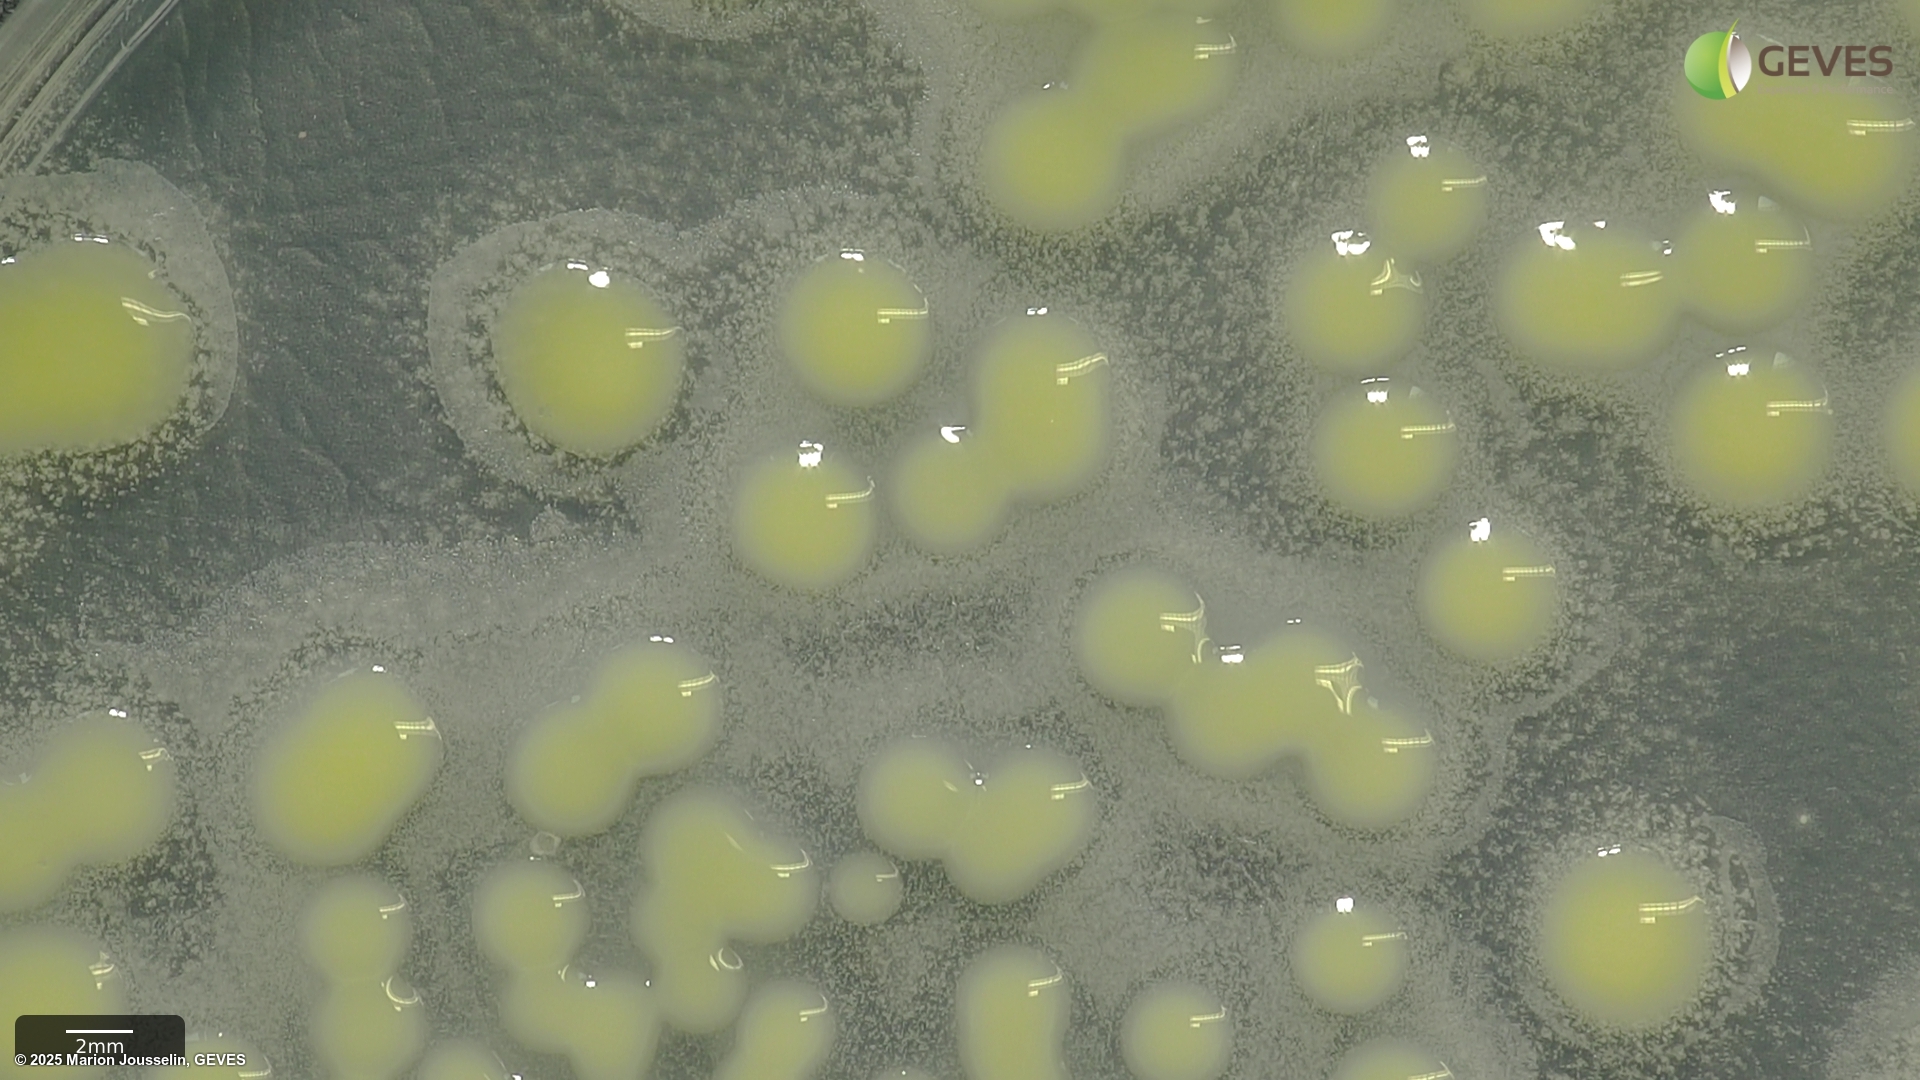
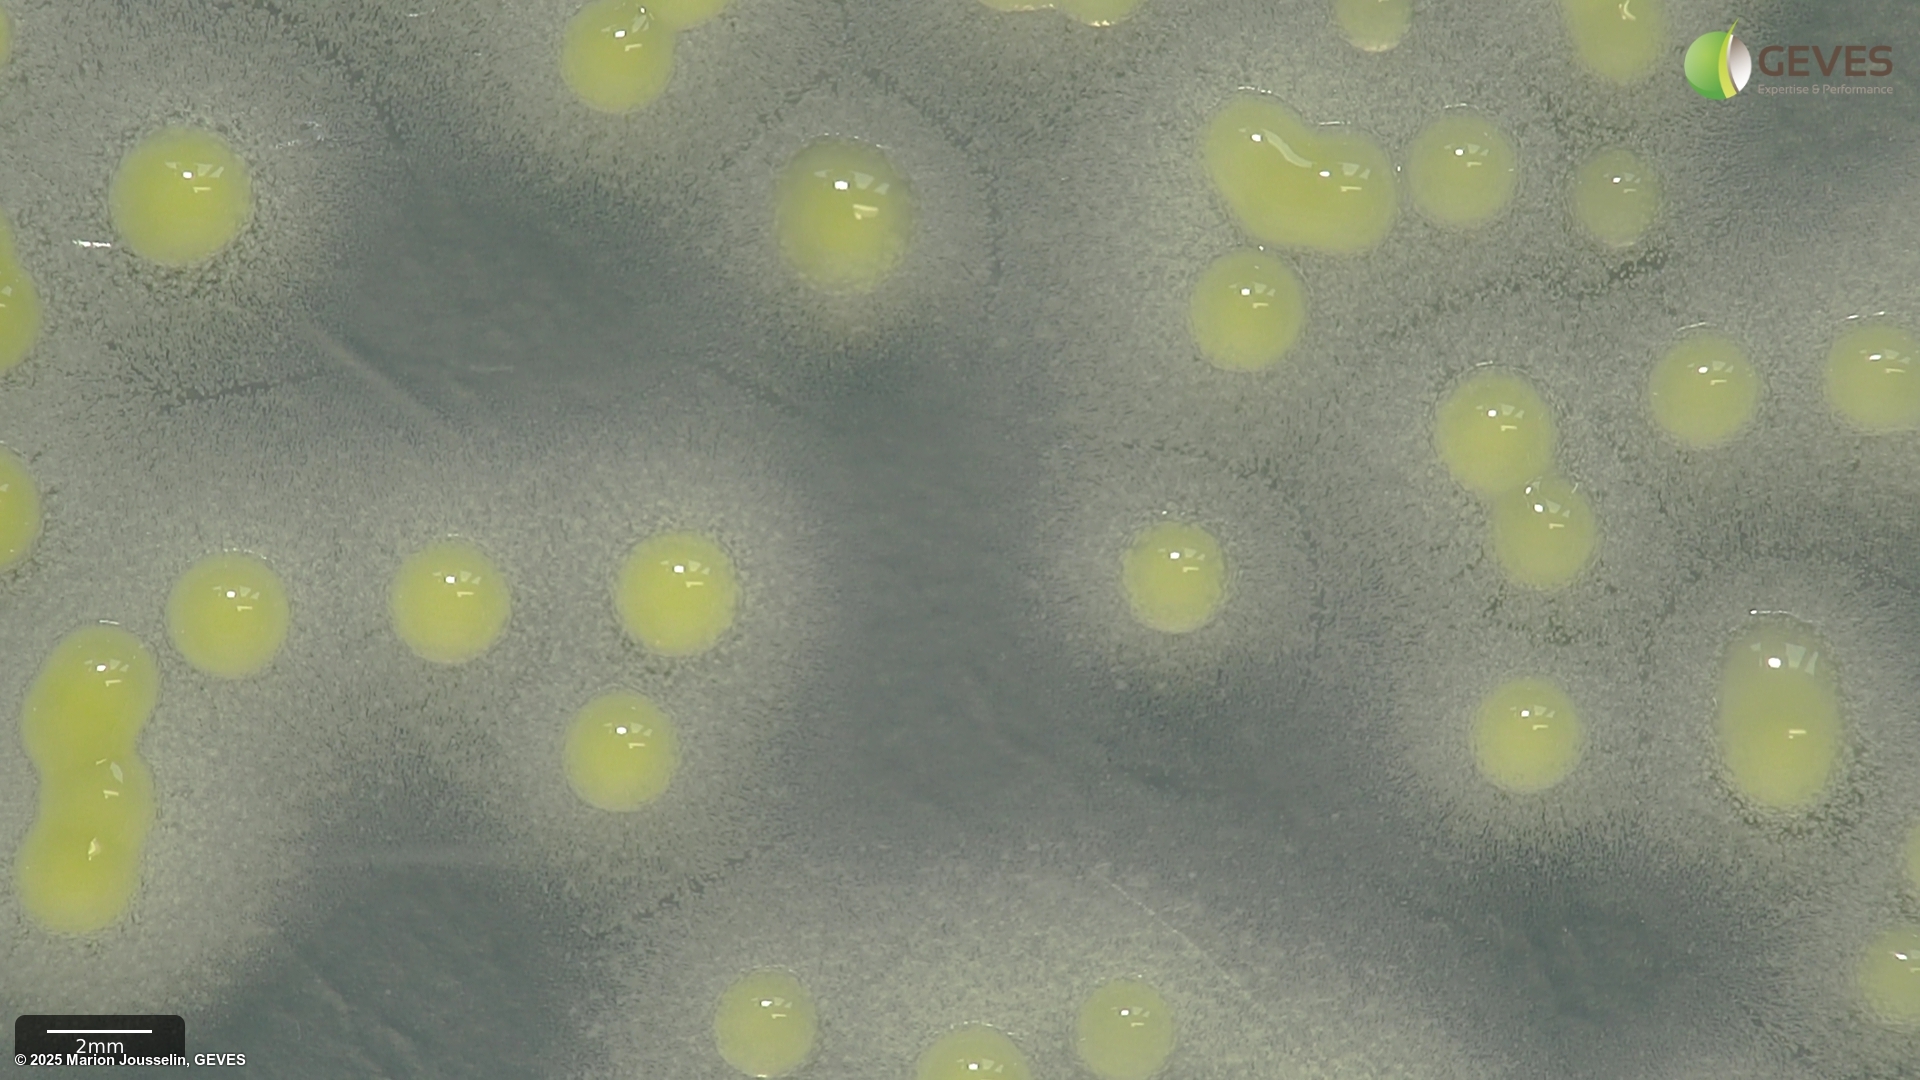
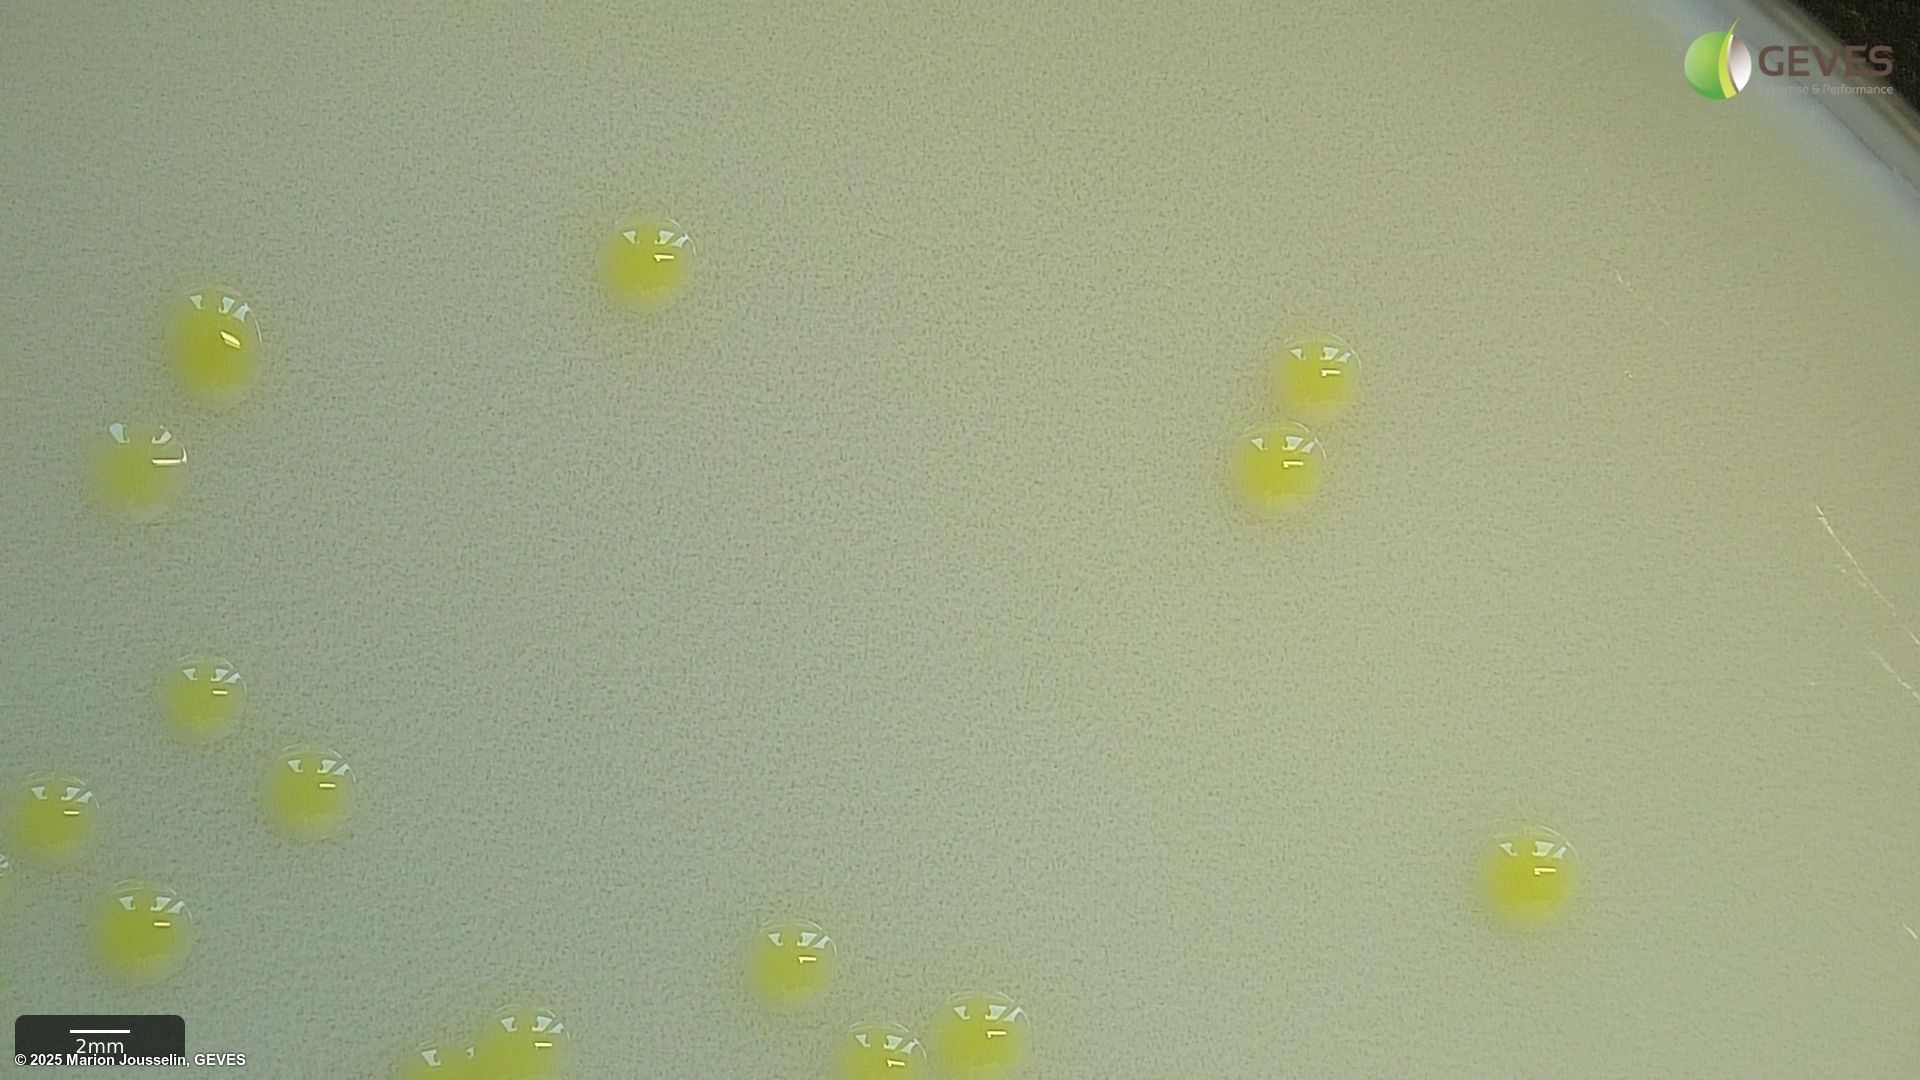
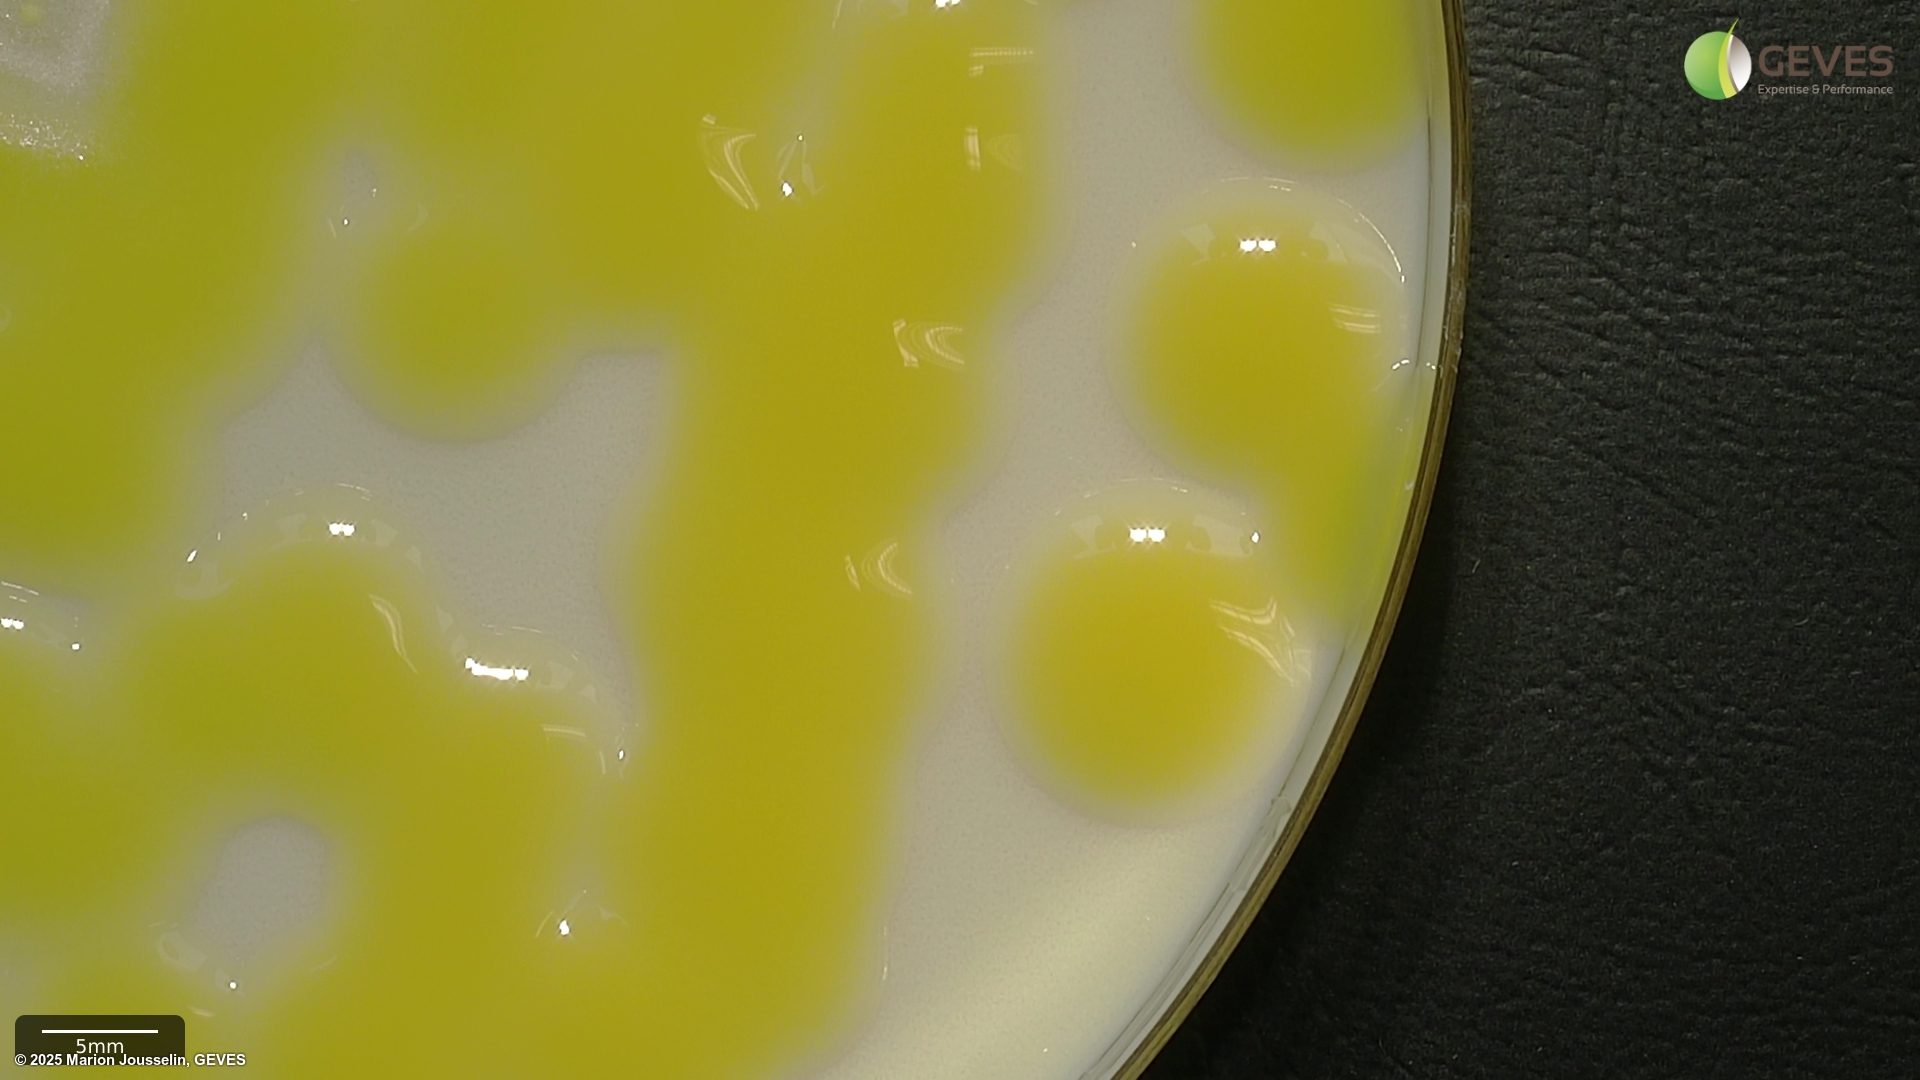

Pathogen
Xanthomonas euvesicatoria pv. euvesicatoria
Overview
|
Scientific name
|
Xanthomonas euvesicatoria pv. euvesicatoria |
|
Genus
|
Xanthomonas |
|
EPPO code
|
XANTEU |
|
Common name
|
Bacterial leaf spot or Scab |
|
Synonyms
|
|
Description
One of the bacteria causing bacterial spot of tomato and pepper, together with Xanthomonas euvesicatoria pv. perforans, Xanthomonas hortorum pv. gardneri, Xanthomonas vesicatoria. (From EPPO code website description)
This description is a ‘stub’ as ISTA has no previous publications on this pathogen. If you would like to contribute and expand this, please feel free to email us at contact@seedhealthtestimagedb.info